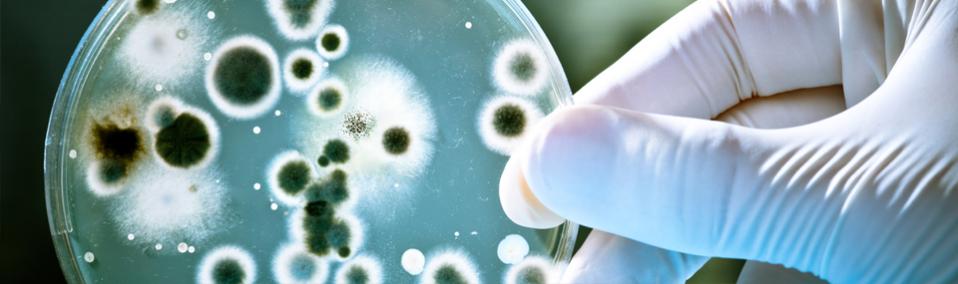

Smellex Bioclean (code 0795)
FOR MICROBIAL TREATMENT OF SEWAGE PIPES, FAT SEPARATORS AND FILTERS OF EXHAUST HOODS
SMELLEX® BIOCLEAN
reduces grease, short- and long-chain aliphatic acids, proteins, lipids and carbohydrates and decreases the formation of bad odors in consequence of anaerobic biological procresses of degradation like hydrogen sulfide and volatile rancidly seeming aliphatic acids. SMELLEX® BIOCLEAN reduces conspicuous greases and deposits. Pipes, filters of exhaust hoods and separators will not be damaged by this environmentally friendy formulation.
SMELLEX® BIOCLEAN is ready to use and can be applied manually or applying an automatic dosage-system. Temperature range for application: 5 – 45 °C
APPLICATION
Apply Smellex® Bioclean undiluted into the systems, which should be cleaned.
FOR APPLICATION
• Fat separators:
– the first application 1.5 l/m3 (volume of fat separator)
• Regular application:
– in case of 400-500 meals per day approx. 0.4 l per day
– in case of 2000 meals per day approx. 1.5 l per day
• Drain pipes:
– the first application approx. 0.4 l per week
– regular application approx. 0.1 l per week
• Filters of exhaust hoods:
– at first application: remove rugh dirt, spray and reinstall the filter. Afterwards rinse with warm water 14- day
– regular application: spray on filter every evening while the exhaust hood is running
ATTENTION:
SMELLEX® BIOCLEAN should not be applied in case of temperatures under 5 °C und in case of direct sunlight, because otherwise the efficiency of the microorganisms could not be guaranteed any more.
Please store frost-free and protected against light.
TECHNICAL DATA
Consistency: cream-colored, odor-free liquid
Density (20 °C): 1.06 g/cm³
pH-value (conc. 20 °C): 8.0 – 9.0
Flash point: unapplicable
Effective pH-range: 4.5 – 8.5
Item-No. 0795
INGREDIENTS
tensides, non pathogene microorganisms Storability: at least 6 months in case of storage from +5 up to +30 °C
